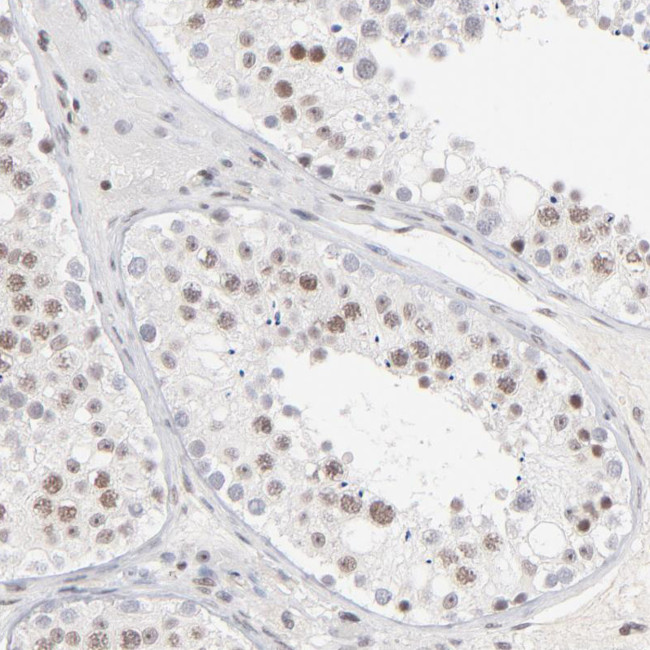
ZNF143 Antibody in Immunohistochemistry (Paraffin) (IHC (P))

Search
Invitrogen
ZNF143 Polyclonal Antibody
{{$productOrderCtrl.translations['antibody.pdp.commerceCard.promotion.promotions']}}
{{$productOrderCtrl.translations['antibody.pdp.commerceCard.promotion.viewpromo']}}
{{$productOrderCtrl.translations['antibody.pdp.commerceCard.promotion.promocode']}}: {{promo.promoCode}} {{promo.promoTitle}} {{promo.promoDescription}}. {{$productOrderCtrl.translations['antibody.pdp.commerceCard.promotion.learnmore']}}
产品信息
PA5-51877
种属反应
宿主/亚型
分类
类型
抗原
偶联物
形式
浓度
规格
纯化类型
保存液
内含物
保存条件
运输条件
RRID
产品详细信息
Immunogen sequence: TQSGLSQQVT LISQDGTQHV NISQADMQAI GNTITMVTQD GTPITVPAHD AVISSAGTHS VAMVTAEGTE GQQVAIVAQD LAAFHTASSE MGHQQHSHHL VTTETRPLTL VATSNGTQIA VQLGEQPSLE EAIRIASRIQ QGET
Highest antigen sequence identity to the following orthologs: Mouse - 99%, Rat - 98%.
靶标信息
Transcriptional activator. Activates the gene for selenocysteine tRNA (tRNAsec). Binds to the SPH motif of small nuclear RNA (snRNA) gene promoters. Participates in efficient U6 RNA polymerase III transcription via its interaction with CHD8.
仅用于科研。不用于诊断过程。未经明确授权不得转售。
篇参考文献 (0)
生物信息学
蛋白别名: hStaf; SBF; ZNF143; Staf; Selenocysteine tRNA gene transcription-activating factor; SPH-binding factor; transcriptional activator Staf; unnamed protein product; Zinc finger protein 143
基因别名: pHZ-1; SBF; STAF; ZNF143
UniProt ID: (Human) P52747
Entrez Gene ID: (Human) 7702